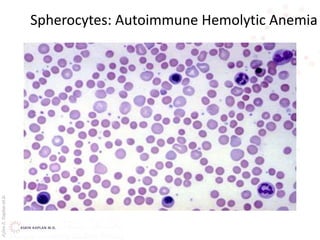
AşkınK.KaplanM.D.
Spherocytes: Autoimmune Hemolytic Anemia
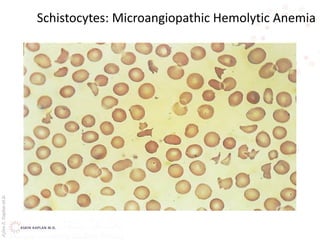
AşkınK.KaplanM.D.
Schistocytes: Microangiopathic Hemolytic Anemia

This document provides an overview of hemolytic anemia, including definitions, classifications, causes, signs and symptoms, and diagnostic tests. It discusses extravascular and intravascular hemolysis, inherited and acquired hemolytic anemias, specific conditions like glucose-6-phosphate dehydrogenase deficiency, autoimmune hemolytic anemia, microangiopathic hemolytic anemia, and paroxysmal nocturnal hemoglobinuria. Physical exam findings of anemia and hemolysis are outlined. Diagnostic tests for hemolytic anemia including blood counts, chemistries, peripheral smear, Coombs test, and hemoglobin electrophoresis are also summarized.